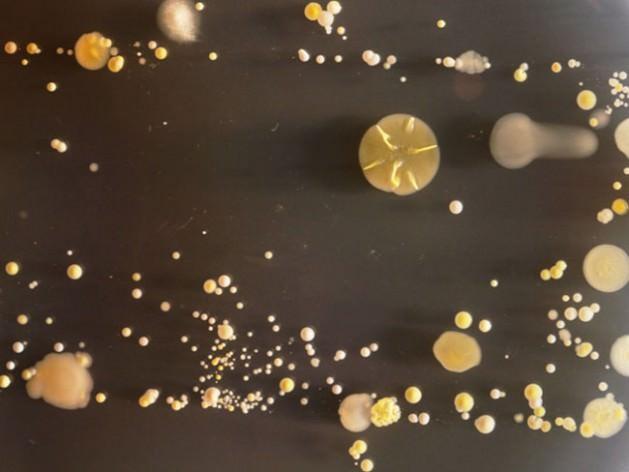
Üniversiteden Doktor Simon Park, cep telefonlarının sadece iletişim aracı olmadığını, bizim kişisel izlerimizi de taşıdığını söylüyor. Tabii aynı zamanda yediklerimizi, içtiklerimizi de telefonlara bir şekilde bulaştırıyoruz.

Cep telefonunda yaşayan canlılar
27.02.2013
15:15
Üniversiteden Doktor Simon Park, cep telefonlarının sadece iletişim aracı olmadığını, bizim kişisel izlerimizi de taşıdığını söylüyor. Tabii aynı zamanda yediklerimizi, içtiklerimizi de telefonlara bir şekilde bulaştırıyoruz.